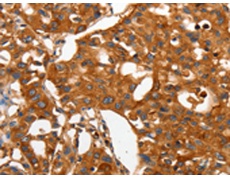
一抗

英文名稱(chēng): Anti-CAP2 rabbit polyclonal antibody
抗 原: CAP2
相關(guān)類(lèi)別: 一抗
標(biāo) 記 物: Unconjugate
克隆類(lèi)型: rabbit polyclonal
技術(shù)規(guī)格
|
Background: |
This gene was identified by its similarity to the gene for human adenylyl cyclase-associated protein. The function of the protein encoded by this gene is unknown. However, the protein appears to be able to interact with adenylyl cyclase-associated protein and actin. |
|
Applications: |
ELISA, WB, IHC |
|
Name of antibody: |
CAP2 |
|
Immunogen: |
Fusion protein of human CAP2 |
|
Full name: |
cyclase associated actin cytoskeleton regulatory protein 2 |
|
SwissProt: |
P40123 |
|
ELISA Recommended dilution: |
1000-5000 |
|
IHC positive control: |
Human lung cancer and Human ovarian cancer |
|
IHC Recommend dilution: |
50-200 |
|
WB Predicted band size: |
53 kDa |
|
WB Positive control: |
Human fetal muscle tissue |
|
WB Recommended dilution: |
200-1000 |


 購(gòu)物車(chē)
購(gòu)物車(chē) 幫助
幫助
 021-54845833/15800441009
021-54845833/15800441009